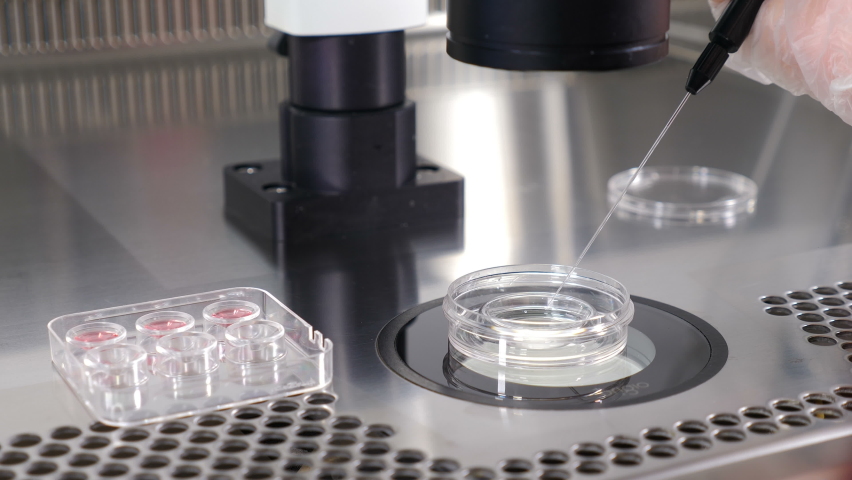

Лабораторные манипуляции
Лабораторные манипуляции 98 фотографий
Форма 003 у приказ
Коробки своими руками поэтапно
Заснял маму на телефон
Electrolux cpe6420kx
Отель альфа саммер анапа сайт
Гонки на лопатах пермский край
Как кричат волнистые попугаи
Бесплатные юристы по телефону круглосуточно горячая
Тулгу телефон приемной комиссии
Другого соника exe
Приключения хомы книга
Гидроксид лития связь
Придаток яичка у детей
Пицца из тортильи на сковороде рецепты
Признаки бактерий и вирусов биология 5
Можно ли останавливаться на желтой линии
Мама с короткой стрижкой видео
Есть ли планета сатурн
Какими продуктами можно почистить
Лучший водоотталкивающий спрей для обуви